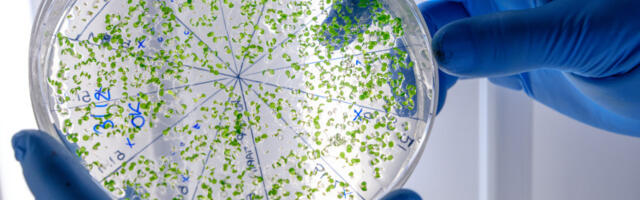
Čudesan antički mikroorganizam otkriven blizu Srbije: Otporan na lekove, ali može spasiti milione života

864 mesto 0
Bakterija nazvana Psychrobacter SC65A.3 pronađena je pod metrima leda u pećini u Rumuniji. Bila je zatrpana oko 5.000 godina i, uprkos tome, pokazuje otpornost na desetak savremenih antibiotika. Naučnice koje su je otkrile su takođe utvrdile da inhibira rast drugih bakterija, uključujući neke od najtežih patogena za suzbijanje. Istraživanje, objavljeno u naučnom časopisu Frontiers in
Članak Čudesan antički mikroorganizam otkriven blizu Srbije: Otporan na lekove, ali može spasiti milione života se pojavljuje
Newsletter svaki dan!
Možete dobiti 10 najvažnijih vesti oko podneva u dnevnom newsletteru. Pritisnite taster i poslaćemo samo najvažnije vesti, bez spama.
LAJKUJ nas na Fejsbuku i neces propustiti najvaznije vesti dana!
Iskusni brazilski vezista Kasemiro, koji ovog ponedeljka proslavio 34. rođendan, sprema se da napusti evropski fudbal posle 14 godina. Pročitaj više ›
3
Arsenal je uspeo da savlada Totenhem sa 4:1 i ode na pet bodova prednosti u odnosu na Mančeste siti na tabeli Premijer lige, iako Građani imaju meč manje. Takvu partiju tima Mikela Artete pohvalio je Geri Nevil. Pročitaj više ›
1
Paolo Dibala nalazi se na raskrsnici, budući da još uvek nije pronašao zajednički jezik sa Romom oko produžetka saradnje. Pročitaj više ›
0
U mnogim svetskim medijima se često pominje kako se neke zemlje „nalaze među najpametnijima“, ali kada pogledamo podatke vezane za Srbiju — slika je mnogo realnija i prikazuje različite pristupe merenju inteligencije. Pročitaj više ›
0 novajlija
Postojalo je vreme kada trening grudi nije bio zamisliv bez tri ugla potiska: ravnog, kosog i obrnutog... Pročitaj više ›
0 novajlija
Polovan luksuzni automobil uvek izgleda kao dobra ideja. Velika limuzina, premium oznaka, cena koja deluje sumnjivo povoljno. Sve dok se ne pojavi — račun iz ovlašćenog servisa… Pročitaj više ›
0 novajlija
Državna korporacija Roskosmos zvanično je otvorila novi konkurs za prijem kandidata u kosmonautsko odeljenje, a kriterijumi su, kao i uvek, izuzetno strogi… Pročitaj više ›
0 novajlija
Posle epizode u NBA ligi, gde je bio član Atlante, talentovani srpski košarkaš Nikola Đurišić je na pragu saradnje sa crveno-belima, saznaje Meridian sport. Čim je rastanak bio izvestan, predsednik kluba sa Malog Kalemegdana Željko Drčelić je svim silama krenuo po bivšeg đaka Mege, koji je dao zeleno svetlo i očekuje se da stavi potpis [...] Pročitaj više ›
0 novajlija
Nikolo Barela, kapiten Intera, prvi je reagovao nakon poraza italijanskog tima u revanš meču plej-ofa za osminu finala Lige šampiona od Bodo Glimta (1:2) i ujedno eliminacije Neroazura. Pročitaj više ›
0 sveže
Član Udruženja proizvođača mleka Šumadije i Pomoravlja Predrag Veljković saopštio je večeras kasno u vanrednom obraćanju medijima da je počela represija policije nad poljoprivrednicima koji su učestvovali u današnjoj blokadi puteva. Pročitaj više ›
0 novajlija
Urednica RTS, Sandra Perović tokom trajanja prve polufinalne večeri PZE, stala je pred novinare i otkrila istinu o padu krana u studiju pred početak programa. Pročitaj više ›
0 sveže
Košarkaš Jute Vins Vilijams, neće se vraćati na teren do kraja sezone zbog teške povrede koju je zadobio nakon divljačkog starta igrača Hjuston Roketsa, Tarija Isona. Pročitaj više ›
0 sveže
Fudbaleri azerbejdžanskog Karabaga završili su svoje učešće u Ligi šampiona za ovu sezonu, ali će ostati upamćeni po neslavnom rekordu. Ekipa je primila najviše golova u jednoj sezoni u istoriji ovog takmičenja. Pročitaj više ›
0 sveže
Ispisao je Mirko Ivanić, a i dalje piše, jedne od najlepših stranica u istoriji Crvene zvezde. Zaslužio je i kapitensku traku našeg najtrofejnijeg kluba, a sve je moglo da bude potpuno drugačije za momka iz Bačkog Jarka. Naime, bivši igrač i trener Partizana Ljubinko Drulović, gostujući u podkastu „AktuelA“, otkrio je da je nameravao da... Članak Drulović otkrio: Ivanića smo hteli da dovedemo u Partizan, videli smo ga kao zamenika... Pročitaj više ›
0 novajlija
Mika Murinen se neće vraćati više u Partizan, što je i sam danas potvrdio. Trenutno se nalazi sa reprezentacijom Finske, a o njegovom odlasku iz Partizana govorili su tamošnji selektor Lasi Tuovi i kapiten Sasu Salin, nekada dugogodišnji igrač ljubljanske Olimpije. – To je Mikina lična stvar. Mislim da je razgovarao sa ljudima koji su […] Pročitaj više ›
0 novajlija
Град Загреб поднеће уставну тужбу Уставном суду Хрватске против владе Хрватске Pročitaj više ›
0 novajlija
Prvo polufinale PZE 2026 emitovano je večeras, 24. februara, a nakon što je završeno glasanje u revijalnom delu pevao je Daniel Kajmakoski. Pročitaj više ›
0 sveže
Večeras je u Beogradu održana premijera filma "Biće novih leta" nakon što su crvenim tepihom prošetali glavni protagonisti ostvarenja Gvozdena Đurića. Pročitaj više ›
0 sveže
Dvojica bivših policajaca, koji su radili u noćnoj smeni brigade za narkotike, uhapšeni su u decembru 2022. godine i bili su u pritvoru, nakon čega su pušteni da se brane sa slobode. Pročitaj više ›
0 sveže
Tri dana nakon što je prijavljen nestanak i pokrenuta zvanična potraga za dvojicom ribolovaca, Stefanom Krstićem (38) iz sela Vučje i Slavišom Antićem (47) iz sela Crcavac, koji su nestali na jezeru Barje kod Leskovca, pronađena su njihova tela umotana u ribarsku mrežu, čime je, nažalost, okončana višednevna drama koja je potresla porodice i prijatelje. Članak Tela dvojice ribolovaca nađena umotana u ribarsku mrežu: Oglasila se rođaka se pojavljuje prvo... Pročitaj više ›
88
U Srbiji će u ponedeljak, 23. februara, preovlađivati umereno do potpuno oblačno vreme, uz blagi porast temperature i bez padavina, dok se na jugu zemlje u jutarnjim satima očekuje vedro uz slab mraz. Jutarnja temperatura kretaće se od minus tri, a najviša dnevna do 17 stepeni, saopštio je Republički hidrometeorološki zavod. Vetar će biti slab Članak Posle slabog mraza prolećne temperature: Predveče se kvari vreme u delu zemlje se pojavljuje... Pročitaj više ›
62
Na restoran u Zaplanjskoj ulici, kod broja 41a, na Voždovcu sinoć je oko dva sata posle ponoći bačen je Molotovljev koktel, piše Blic. Prema prvim informacijama, nepoznata osoba bacila je zapaljivu napravu na objekat. Povređenih nema, dok je pričinjena materijalna šteta. Policija je izašla na lice mesta, obavila uviđaj i radi na utvrđivanju svih okolnosti Članak Molotovljev koktel bačen na restoran na Voždovcu se pojavljuje prvo na Objektiv. Pročitaj više ›
57
Prema podacima Republičkog hidrometeorološkog zavoda, tokom večeri i noći očekuje se oblačno i hladno vreme. U nižim predelima mestimično je moguća slaba kiša ili sneg, dok se na planinama predviđa slab sneg. U severnim krajevima padavine će u drugom delu noći prestati, ali će se ponegde zadržati niska oblačnost i sumaglica. Duvaće slab vetar zapadnog Članak Stiže pad temeprature: Oglasio se RHMZ, evo šta se očekuje pred jutro se pojavljuje... Pročitaj više ›
55
Mladenovačko preduzeće TZR & Katarina, koje se bavi proizvodnjom kakaa, čokolade i konditorskih proizvoda oglasilo je drugu prodaju svoje imovine metodom javnog nadmetanja u okviru stečajnog postupka. Ponuđena je pokretna imovina koja obuhvata kompletnu opremu za proizvodnju kakaa, čokolade i konditorskih proizvoda u mestu Kovačevac. Procena vrednosti imovine prelazi 3,8 miliona dinara bez obračunatog PDV-a. Članak Prodaje se fabrika čokolade u Srbiji: Košta kao jedna garaža u Beogradu se pojavljuje... Pročitaj više ›
54
Zašto se meso ribe gotovo uvek zalepi za dno tiganja i u čemu greše čak i iskusni kuvari? Reč je o nizu sitnih, ali sudbonosnih grešaka – od pripreme filea, preko temperature tiganja, do samog rukovanja uljem. Pravilno sušenje fileta Pre nego što riba uopšte dotakne tiganj, veoma je važno da bude potpuno suva. Vlaga Članak Kako da vam se riba više nikad ne zalepi za tiganj se pojavljuje prvo... Pročitaj više ›
54
Plavska policija uhapsila jeR.Đ (26) iz tog grada zbog sumnje da je sedamdesetogodišnjoj osobi ukrala 70.000 evra, 1.100 dolara i 300 švajcarskih franaka. Policija je pronašla više od polovine novca koji osumnjičena nije uspela da potroši i vozilo koje je kupljeno otuđenim novcem. Službenici Regionalnog centra bezbednosti „Sever“ – Odeljenja bezbednosti Plav su u roku Članak Crnogorka osumnjičena za krađu 70.000 evra: Sebi kupila luksuzne stvari, dečku Golf 7, ovako... Pročitaj više ›
44
Danas Srpska pravoslavna crkva proslavlja Svetu mučenicu Agatiju. Rodila se u porodici imućnih, ali uglednih i dobrih ljudi u sicilijanskom gradu Palermu, a priča kaže da je reč bila o prelepoj devojci koja je od malih nogu živela u skladu sa hrišćanskim vrednostima. Život joj se iz korena promenio kada je car Decije Trajan počeo Članak Danas vernici slave Svetu mučenicu Agatiju: Treba izaći iz kuće i ispuniti ovaj običaj... Pročitaj više ›
41
Na međunarodnoj Olimpijadi Sjedinjenih Američkih Država iz matematike, Vuk Nikolov osvojio je zlatnu medalju i titulu apsolutnog pobednika za učenike trećeg i četvrtog razreda gimnazije. Da bi sinu obezbedio odlazak na takmičenje, otac je napravio link za donacije, a ostatak troškova je sam obezbedio. I nije pogrešio. Takmičenje se održava svakih šest meseci. A Vuk Članak Vuk osvojio zlatnu medalju i titulu apsolutnog pobednika matematičke olimpijade u SAD se pojavljuje... Pročitaj više ›
41
Gotovo 40 odsto ljudi sa povišenim LDL-om, takozvanim “lošim“ holesterolom, uopšte ne zna da ima taj problem. Ako su vrednosti povišene, promena ishrane jedan je od ključnih koraka za smanjenje rizika od srčanih bolesti. Osim hrane, važno je obratiti pažnju i na ono što se pije. Prema preporukama nutricionista, jedan jutarnji napitak posebno se ističe. Članak Savet nutricionista: Najbolji jutarnji napitak za snižavanje holesterola se pojavljuje prvo na Objektiv. Pročitaj više ›
30
Najpopularniji izvori
|
|
100% 97 |
| Ženski magazin | 0% |
|
|
0% |
|
|
0% 0 |
|
|
0% 0 |
| Pogledaj izvore » | |
LAJKUJ nas na Fejsbuku i neces propustiti najvaznije vesti dana!
25.02.2026 00:19
Ažurirano: 00:15.
Pozicija vesti je ažurirana u: 01:11
Šta je Svetionik.com?
Svetionik.com ti donosi najpopularnije vesti sa srpskih news portala u tabeli u realnom vremenu.
Prijatelji sajta
Ocenjivanje slika
Upoznavanje preko Interneta
Prevoz do aerodroma
Honorarni poslovi Beograd
Pročitaj o nama u FAQ sekciji
In another language
Српски / srpski Eesti keel (Eesti uudised) Русский язык (новости Эстонии) Українська мова (новини Естонії)